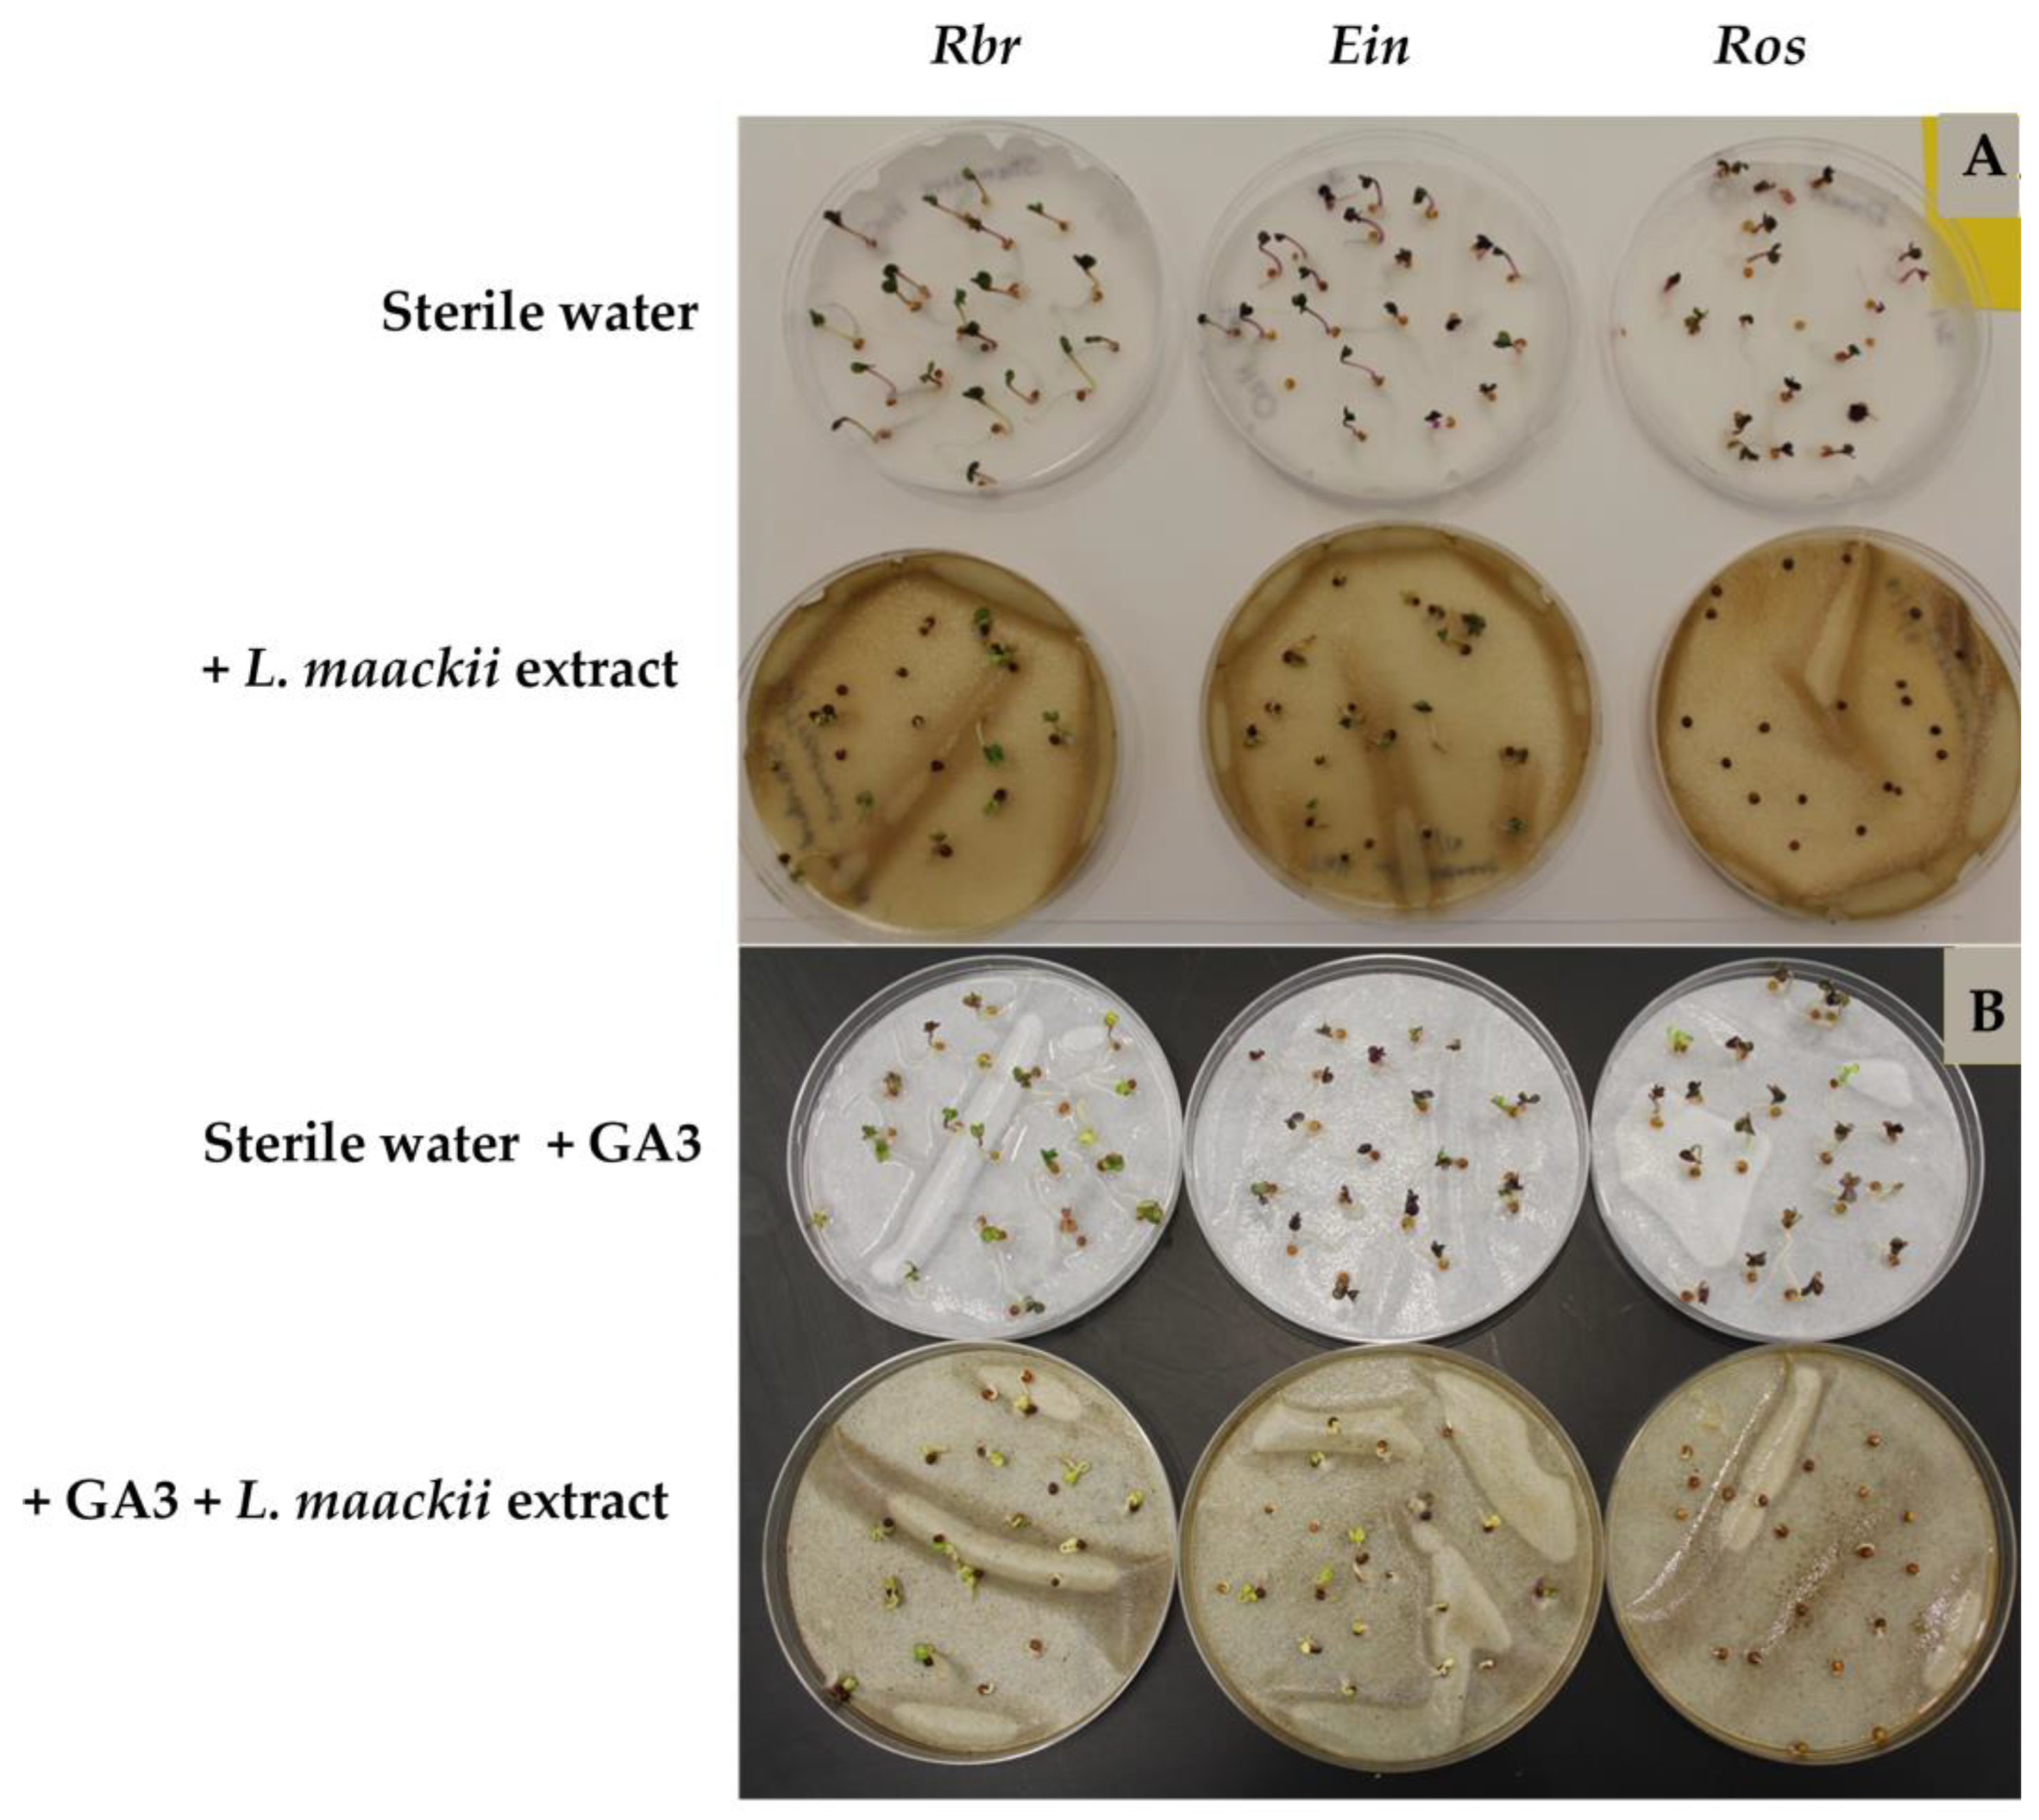
Plants 12 01014 g004

The First Evidence of Gibberellic Acid’s Ability to Modulate Target Species’ Sensitivity to Honeysuckle (Lonicera maackii) Allelochemicals
Abstract
:1. Introduction
2. Results
2.1. Lonicera maackii Leaf Extracts Inhibit Brassica rapa Seed Germination
2.2. Gibberellic Acid Influences Brassica rapa’s Sensitivity to Lonicera maackii Allelopathic Effects
2.3. Apigenin, Luteolin, and Their Combination Exert Varying Effects on the Germination and Growth of B. rapa Seeds
3. Discussion
4. Materials and Methods
4.1. Plant Material and Growth Conditions
4.1.1. Lonicera maackii Leaf Collection and Extraction
4.1.2. Brassica rapa Varieties and Growth Conditions
4.2. Germination and Seedling Development Bioassays
4.2.1. Concentration Dependence and Seasonal Variation in the Effects of Lonicera maackii Extracts on Brassica Seeds
4.2.2. The Impact of the Plant Growth Hormones, Gibberellins, on Brassica Seed Responses to Lonicera maackii Leaf Extracts
4.2.3. Apigenin, Luteolin, and Their Combined Effects on Brassica Seed Germination and Early Seedling Development
4.3. Statistical Analysis
Author Contributions
Funding
Data Availability Statement
Acknowledgments
Conflicts of Interest
References
- Ruesink, J.L.; Parker, I.M.; Groom, M.J.; Kareiva, P.M. Reducing the risks of non-indigenous species introductions. BioScience 1995, 45, 465–477. [Google Scholar] [CrossRef]
- Wilcove, D.S.; Rothstein, D.; Dubow, J.; Phillips, A.; Losos, E. Quantifying threats to imperiled species in the United States. BioScience 1998, 48, 607–615. [Google Scholar] [CrossRef] [Green Version]
- Eviner, V.T.; Garbach, K.; Baty, J.H.; Hoskinson, S.A. Measuring the effects of invasive plants on ecosystem services: Challenges and prospects. Invas. Plant Sci. Mana. 2012, 5, 125–136. [Google Scholar] [CrossRef]
- Kaushik, P.; Pati, P.K.; Khan, M.L.; Khare, P.K. Plant functional traits best explain invasive species’ performance within a dynamic Ecosystem—A review. Trees People 2022, 8, 100260. [Google Scholar] [CrossRef]
- Levine, J.M. Species Diversity and Biological Invasions: Relating local process to community pattern. Science 2000, 288, 852–854. [Google Scholar] [CrossRef] [Green Version]
- Collier, M.H.; Vankat, J.L.; Hughes, M.R. Diminished plant richness and abundance below Lonicera maackii, an invasive shrub. Am. Midl. Nat. 2002, 147, 60–71. [Google Scholar] [CrossRef]
- Crooks, J.A. Characterizing ecosystem-level consequences of biological invasions: The role of ecosystem engineers. Oikos 2002, 97, 153–166. [Google Scholar] [CrossRef] [Green Version]
- Callaway, R.M.; Ridenour, W.M. Novel weapons: Invasive success and the evolution of increased competitive ability. Front. Ecol. Environ. 2004, 2, 436–443. [Google Scholar] [CrossRef]
- Pimentel, D.; Zuniga, R.; Morrison, D. Update on the environmental and economic costs associated with alien-invasive species in the United States. Ecol. Econ. 2005, 52, 273–288. [Google Scholar] [CrossRef]
- Hejda, M.; Pyšek, P.; Jarošík, V. Impact of invasive plants on the species richness, diversity, and composition of invaded communities. J. Ecol. 2009, 97, 393–403. [Google Scholar] [CrossRef]
- Zeng, R.S. Allelopathy—The solution is indirect. J. Chem. Ecol. 2014, 40, 515–516. [Google Scholar] [CrossRef] [PubMed]
- Tataridas, A.; Jabran, K.; Kanatas, P.; Oliveira, R.S.; Freitas, H.; Travlos, I. Early detection, herbicide resistance screening, and integrated management of invasive plant species: A review. Pest Manag. Sci. 2022, 78, 3957–3972. [Google Scholar] [CrossRef] [PubMed]
- Forner, W.G.; Zalba, S.M.; Guadagnin, D.L. Methods for prioritizing invasive plants in protected areas: A systematic review. Nat. Areas J. 2022, 42, 69–78. [Google Scholar] [CrossRef] [PubMed]
- Ngondya, I.B.; Munishi, L.K. Managing invasive plants through a nature-based approach in complex landscapes. Trends Ecol. Evol. 2022, 37, 284–288. [Google Scholar] [CrossRef]
- Vankat, J.L.; Roy, D.G. Landscape invasibility by exotic species. In Applying Landscape Ecology in Biological Conservation; Gutzwiller, K.J., Ed.; Springer: New York, NY, USA, 2002; pp. 171–191. [Google Scholar] [CrossRef]
- McNeish, R.E.; McEwan, R.W. A review on the invasion ecology of Amur honeysuckle (Lonicera maackii, Caprifoliaceae) a case study of ecological impacts at multiple scales. J. Torrey Bot. Soc. 2016, 143, 367–385. [Google Scholar] [CrossRef] [Green Version]
- Zhang, B.; Yang, R.; Liu, C.-Z. Microwave-assisted extraction of chlorogenic acid from flower buds of Lonicera japonica Thunb. Sep. Purif. Technol. 2008, 62, 480–483. [Google Scholar] [CrossRef]
- Shang, X.; Pan, H.; Li, M.; Miao, X.; Ding, H. Lonicera japonica Thunb.: Ethnopharmacology, phytochemistry and pharmacology of an important traditional Chinese medicine. J. Ethnopharmacol. 2011, 138, 1–21. [Google Scholar] [CrossRef]
- Li, M.; Wang, Y.; Jin, J.; Dou, J.; Guo, Q.; Ke, X.; Zhou, C.; Guo, M. Inhibitory activity of Honeysuckle extracts against influenza a virus in vitro and in vivo. Virol. Sin. 2021, 36, 490–500. [Google Scholar] [CrossRef]
- Kang, M.; Jung, I.; Hur, J.; Kim, S.H.; Lee, J.H.; Kang, J.-Y.; Jung, K.C.; Kim, K.S.; Yoo, M.C.; Park, D.-S.; et al. The analgesic and anti-inflammatory effect of WIN-34B, a new herbal formula for osteoarthritis composed of Lonicera japonica Thunb and Anemarrhena asphodeloides BUNGE in vivo. J. Ethnopharmacol. 2010, 131, 485–496. [Google Scholar] [CrossRef]
- Nikzad-Langerodi, R.; Ortmann, S.; Pferschy-Wenzig, E.M.; Bochkov, V.; Zhao, Y.M.; Miao, J.H.; Saukel, J.; Ladurner, A.; Heiss, E.H.; Dirsch, V.M.; et al. Assessment of anti-inflammatory properties of extracts from Honeysuckle (Lonicera sp. L., Caprifoliaceae) by ATR-FTIR spectroscopy. Talanta 2017, 175, 264–272. [Google Scholar] [CrossRef]
- Shan, J.; Fu, J.; Zhao, Z.; Kong, X.; Huang, H.; Luo, L.; Yin, Z. Chlorogenic acid inhibits lipopolysaccharide-induced cyclooxygenase-2 expression in RAW264.7 cells through suppressing NF-ΚB and JNK/AP-1 activation. Int. Immunopharmacol. 2009, 9, 1042–1048. [Google Scholar] [CrossRef] [PubMed]
- Yuan, Y.; Wang, Z.; Jiang, C.; Wang, X.; Huang, L. Exploiting genes and functional diversity of chlorogenic acid and luteolin biosyntheses in Lonicera japonica and their Substitutes. Gene 2014, 534, 408–416. [Google Scholar] [CrossRef] [PubMed]
- Zhou, X.; He, G.; Ma, J.; Tang, M.; Tian, G.; Gong, X.; Zhang, H.; Kui, L. Protective effect of a novel polysaccharide from Lonicera japonica on cardiomyocytes of mice injured by hydrogen peroxide. BioMed. Res. Int. 2020, 2020, 5279193. [Google Scholar] [CrossRef] [PubMed]
- Luken, J.O.; Thieret, J.W. Amur honeysuckle, its fall from grace. BioScience 1996, 46, 18–24. [Google Scholar] [CrossRef] [Green Version]
- USDA, NRCS. The Plants Database; National Plant Data Team: Greensboro, NC, USA, 2022. Available online: http://plants.usda.gov (accessed on 21 November 2022).
- National Library of Medicine, National Center for Biotechnology Information (NCBI-NLM), Genome Assembly RIT_L_maackii_v1.0, GCA_023512865.1. Available online: https://www.ncbi.nlm.nih.gov/data-hub/genome/GCA_023512865.1/ (accessed on 25 November 2022).
- Luken, J.O. Population structure and biomass allocation of the naturalized shrub Lonicera maackii (Rupr.) Maxim. in forest and open habitats. Am. Midl. Nat. 1988, 119, 258–267. [Google Scholar] [CrossRef]
- Luken, J.O.; Goessling, N. Seedling distribution and potential persistence of the exotic shrub Lonicera maackii in fragmented forests. Am. Midl. Nat. 1995, 133, 124–130. [Google Scholar] [CrossRef]
- Hutchinson, T.F.; Vankat, J.L. Landscape structure and spread of the exotic shrub Lonicera maackii (Amur honeysuckle) in southwestern Ohio forests. Am. Midl. Nat. 1998, 139, 383–390. [Google Scholar] [CrossRef]
- Deering, R.H.; Vankat, J.L. Forest colonization and developmental growth of the invasive shrub Lonicera maackii. Am. Midl. Nat. 1999, 141, 43–50. [Google Scholar] [CrossRef]
- Gould, A.M.A.; Gorchov, D.L. Effects of the exotic invasive shrub Lonicera maackii on the survival and fecundity of three species of native annuals. Am. Midl. Nat. 2000, 144, 36–50. [Google Scholar] [CrossRef]
- Luken, J.O.; Mattimiro, D.T. Habitat-specific resilience of the invasive shrub Amur honeysuckle (Lonicera maackii) during repeated clipping. Ecol. Appl. 1991, 1, 104–109. [Google Scholar] [CrossRef]
- Luken, J.O.; Tholemeier, T.C.; Kunkel, B.A.; Kuddes, L.M. Branch architecture plasticity of Amur honeysuckle (Lonicera maackii (Rupr.) Herder): Initial response in extreme light environments. Bull. Torrey Bot. Club 1995, 122, 190. [Google Scholar] [CrossRef]
- Luken, J.O.; Kuddes, L.M.; Tholemeier, T.C.; Haller, D.M. Comparative responses of Lonicera maackii (Amur honeysuckle) and Lindera benzoin (Spicebush) to increased light. Am. Midl. Nat. 1997, 138, 331. [Google Scholar] [CrossRef]
- Lieurance, D.; Landsbergen, K. The influence of light habitat on the physiology, biomass allocation, and fecundity of the invasive shrub Amur honeysuckle (Lonicera maackii, Caprifoliaceae). J. Torrey Bot. Soc. 2016, 143, 415. [Google Scholar] [CrossRef] [Green Version]
- Schuster, M.J.; Dukes, J.S. Rainfall variability counteracts N addition by promoting invasive Lonicera maackii and extending phenology in prairie. Ecol. Appl. 2017, 27, 1555–1563. [Google Scholar] [CrossRef]
- Sun, Q.; Lai, L.; Zhou, J.; Liu, X.; Zheng, Y. Eco-physiological leaf traits of forty-seven woody species under long-term acclimation in a botanical garden. Plants 2022, 11, 725. [Google Scholar] [CrossRef]
- Fang, X.; Wang, K.; Sun, X.; Wang, Y.; Zheng, P.; Shi, F. Characteristics of chlorophyll fluorescence in ten garden shrub species under flooding stress. Biologia 2022, 77, 339–350. [Google Scholar] [CrossRef]
- McEwan, R.W.; Birchfield, M.K.; Schoergendorfer, A.; Arthur, M.A. Leaf phenology and freeze tolerance of the invasive shrub Amur honeysuckle and potential native competitors. J. Torrey Bot. Soc. 2009, 136, 212–220. [Google Scholar] [CrossRef]
- Smith, L.M. Extended leaf phenology in deciduous forest invaders: Mechanisms of impact on native communities. J. Veg. Sci. 2013, 24, 979–989. [Google Scholar] [CrossRef]
- Fridley, J.D.; Craddock, A. Contrasting growth phenology of native and invasive forest shrubs mediated by genome size. New Phytol. 2015, 207, 659–668. [Google Scholar] [CrossRef]
- Bartuszevige, A.M.; Gorchov, D.L. Avian seed dispersal of an invasive shrub. Biol. Invasions 2006, 8, 1013–1022. [Google Scholar] [CrossRef]
- Castellano, S.M.; Gorchov, D.L. White-tailed deer (Odocoileus virginianus) disperse seeds of the invasive shrub, Amur honeysuckle (Lonicera maackii). Nat. Areas J. 2013, 33, 78–80. [Google Scholar] [CrossRef]
- Guiden, P.; Gorchov, D.L.; Nielsen, C.; Schauber, E. Seed dispersal of an invasive shrub, Amur honeysuckle (Lonicera maackii), by white-tailed deer in a fragmented agricultural-forest matrix. Plant Ecol. 2015, 216, 939–950. [Google Scholar] [CrossRef] [Green Version]
- McEwan, R.W.; Rieske, L.K.; Arthur, M.A. Potential interactions between invasive woody shrubs and the gypsy moth (Lymantria dispar), an invasive insect herbivore. Biol. Invasions 2008, 11, 1053–1058. [Google Scholar] [CrossRef]
- Cipollini, D.; Stevenson, R.; Enright, S.; Eyles, A.; Bonello, P. Phenolic metabolites in leaves of the invasive shrub, Lonicera maackii, and their potential phytotoxic and anti-herbivore effects. J. Chem. Ecol. 2008, 34, 144–152. [Google Scholar] [CrossRef]
- Lieurance, D.; Cipollini, D. Damage levels from arthropod herbivores on Lonicera maackii suggest enemy release in its introduced range. Biol. Invasions 2011, 14, 863–873. [Google Scholar] [CrossRef]
- Lieurance, D.; Cipollini, D. Environmental influences on growth and defence responses of the invasive shrub, Lonicera maackii, to simulated and real herbivory in the juvenile stage. Ann. Bot. 2013, 112, 741–749. [Google Scholar] [CrossRef] [Green Version]
- Lieurance, D.; Cipollini, D. Exotic Lonicera species both escape and resist specialist and generalist herbivores in the introduced range in North America. Biol. Invasions 2013, 15, 1713–1724. [Google Scholar] [CrossRef]
- Dorning, M.; Cipollini, D. Leaf and root extracts of the invasive shrub, Lonicera maackii, inhibit seed germination of three herbs with no autotoxic effects. Plant Ecol. 2005, 184, 287–296. [Google Scholar] [CrossRef]
- Cipollini, D.; Dorning, M. Direct and indirect effects of conditioned soils and tissue extracts of the invasive shrub, Lonicera maackii, on target plant performance. Castanea 2008, 73, 166–176. [Google Scholar] [CrossRef]
- Cipollini, K.A.; McClain, G.Y.; Cipollini, D. Separating above- and belowground effects of Alliaria petiolata and Lonicera maackii on the performance of Impatiens capensis. Am. Midl. Nat. 2008, 160, 117–128. [Google Scholar] [CrossRef]
- Cipollini, D.; Stevenson, R.; Cipollini, K. Contrasting effects of allelochemicals from two invasive plants on the performance of a nonmycorrhizal plant. Int. J. Plant Sci. 2008, 169, 371–375. [Google Scholar] [CrossRef] [Green Version]
- McEwan, R.W.; Arthur-Paratley, L.G.; Rieske, L.K.; Arthur, M.A. A Multi-assay comparison of seed germination inhibition by Lonicera maackii and co-occurring native shrubs. Flora Morphol. Distrib. Funct. Ecol. Plants 2010, 205, 475–483. [Google Scholar] [CrossRef]
- Cipollini, K.; Flint, W. Comparing allelopathic effects of root and leaf extracts of invasive Alliaria petiolata, Lonicera maackii and Ranunculus ficaria on germination of three native woodland plants. Ohio J. Sci. 2013, 112, 37–43. Available online: https://kb.osu.edu/bitstream/handle/1811/55690/OJS112N2_37.pdf?sequence=1 (accessed on 25 November 2022).
- Cipollini, K.; Greenawalt Bohrer, M. Comparison of allelopathic effects of five invasive species on two native species. J. Torrey Bot. Soc. 2016, 143, 427–436. [Google Scholar] [CrossRef] [Green Version]
- Trisel, D.E. The invasive shrub, Lonicera maackii (Rupr.) Herder (Caprifoliaceae): Factors leading to its success and its effect on native species. Ph.D. Thesis, Miami University, Oxford, OH, USA, 1997. Available online: https://scholar.google.com/scholar?hl=en&as_sdt=0%2C26&q=Trisel+1997+PhD&btnG= (accessed on 1 December 2022).
- Gorchov, D.L.; Trisel, D.E. Competitive effects of the invasive shrub, Lonicera maackii (Rupr.) Herder (Caprifoliaceae), on the growth and survival of native tree seedlings. Plant Ecol. 2003, 166, 13–24. [Google Scholar] [CrossRef]
- Skulman, B.W.; Mattice, J.D.; Cain, M.D.; Gbur, E.E. Evidence for allelopathic interference of Japanese honeysuckle (Lonicera japonica) to Loblolly and shortleaf pine regeneration. Weed Sci. 2004, 52, 433–439. [Google Scholar] [CrossRef]
- Miller, K.E.; Gorchov, D.L. The invasive shrub, Lonicera maackii, reduces growth and fecundity of perennial forest herbs. Oecologia 2004, 139, 359–375. [Google Scholar] [CrossRef]
- Bauer, J.T.; Shannon, S.M.; Stoops, R.E.; Reynolds, H.L. Context dependency of the allelopathic effects of Lonicera maackii on seed germination. Plant Ecol. 2012, 213, 1907–1916. [Google Scholar] [CrossRef]
- Medina-Villar, S.; Uscola, M.; Pérez-Corona, M.E.; Jacobs, D.F. Environmental stress under climate change reduces plant performance, yet increases allelopathic potential of an invasive shrub. Biol. Invasions 2020, 22, 2859–2881. [Google Scholar] [CrossRef]
- Meiners, S.J. Apparent Competition: An impact of exotic shrub invasion on tree Regeneration. Biol. Invasions 2007, 9, 849–855. [Google Scholar] [CrossRef]
- Hartman, K.M.; McCarthy, B.C. Changes in forest structure and species composition following invasion by a non-indigenous shrub, Amur honeysuckle (Lonicera maackii). J. Torrey Bot. Soc. 2008, 135, 245–259. [Google Scholar] [CrossRef]
- Rodewald, A.D.; Shustack, D.P.; Hitchcock, L.E. Exotic shrubs as ephemeral ecological traps for nesting birds. Biol. Invasions 2009, 12, 33–39. [Google Scholar] [CrossRef]
- Boyce, R.L.; Durtsche, R.D.; Fugal, S.L. Impact of the invasive shrub Lonicera maackii on stand transpiration and ecosystem hydrology in a wetland forest. Biol. Invasions 2011, 14, 671–680. [Google Scholar] [CrossRef]
- Arthur, M.A.; Bray, S.R.; Kuchle, C.R.; McEwan, R.W. The influence of the invasive shrub, Lonicera maackii, on leaf decomposition and microbial community dynamics. Plant Ecol. 2012, 213, 1571–1582. [Google Scholar] [CrossRef]
- McNeish, R.E.; Benbow, M.E.; McEwan, R.W. Riparian invasion of Lonicera maackii influences throughfall chemistry and rainwater availability. Ecol. Res. 2018, 33, 1021–1030. [Google Scholar] [CrossRef]
- Robison, A.L.; Berta, J.L.; Mott, C.L.; Regester, K.J. Impacts of invasive Amur honeysuckle, Lonicera maackii, leaf litter on multiple trophic levels of detritus-based experimental wetlands. Freshw. Biol. 2021, 66, 1464–1474. [Google Scholar] [CrossRef]
- Debeaujon, I.; Koornneef, M. Gibberellin requirement for Arabidopsis seed germination is determined both by testa characteristics and embryonic abscisic acid. Plant Physiol. 2000, 122, 415–424. [Google Scholar] [CrossRef] [PubMed] [Green Version]
- Ogawa, M.; Hanada, A.; Yamauchi, Y.; Kuwahara, A.; Kamiya, Y.; Yamaguchi, S. Gibberellin biosynthesis and response during Arabidopsis seed germination. Plant Cell 2003, 15, 1591–1604. [Google Scholar] [CrossRef] [PubMed] [Green Version]
- Yamauchi, Y.; Ogawa, M.; Kuwahara, A.; Hanada, A.; Kamiya, Y.; Yamaguchi, S. Activation of gibberellin biosynthesis and response pathways by low temperature during imbibition of Arabidopsis thaliana seeds. Plant Cell 2004, 16, 367–378. [Google Scholar] [CrossRef] [PubMed] [Green Version]
- Kucera, B.; Cohn, M.A.; Leubner-Metzger, G. Plant hormone interactions during seed dormancy release and germination. Seed Sci. Res. 2005, 15, 281–307. [Google Scholar] [CrossRef]
- Finch-Savage, W.E.; Leubner-Metzger, G. Seed dormancy and the control of germination. New Phytol. 2006, 171, 501–523. [Google Scholar] [CrossRef] [PubMed]
- Seo, M.; Nambara, E.; Choi, G.; Yamaguchi, S. Interaction of light and hormone signals in germinating seeds. Plant Mol. Biol. 2008, 69, 463–472. [Google Scholar] [CrossRef] [PubMed]
- Finkelstein, R.; Reeves, W.; Ariizumi, T.; Steber, C. Molecular aspects of seed dormancy. Annu. Rev. Plant Biol. 2008, 59, 387–415. [Google Scholar] [CrossRef] [PubMed] [Green Version]
- Yan, D.; Duermeyer, L.; Leoveanu, C.; Nambara, E. The functions of the endosperm during seed germination. Plant Cell Physiol. 2014, 55, 1521–1533. [Google Scholar] [CrossRef]
- Reed, R.C.; Bradford, K.J.; Khanday, I. Seed germination and vigor: Ensuring crop sustainability in a changing climate. Heredity 2022, 128, 450–459. [Google Scholar] [CrossRef] [PubMed]
- Williams, P.H.; Hill, C.B. Rapid-cycling populations of Brassica. Science 1986, 232, 1385–1389. [Google Scholar] [CrossRef] [Green Version]
- Kelly, M.G.; Terrana, S.A. Method to teach age-specific demography with field grown rapid cycling Brassica rapa (Wisconsin Fast Plants). J. Nat. Resour. Life Sci. Educ. 2004, 33, 40–46. [Google Scholar] [CrossRef]
- Kelly, M.G. Characterizing genotype specific differences in survival, growth, and reproduction for field grown, rapid cycling Brassica rapa. Environ. Exp. Bot. 2006, 55, 61–69. [Google Scholar] [CrossRef]
- Callaway, R.M.; Aschehoug, E.T. Invasive plants versus their new and old neighbors: A mechanism for exotic invasion. Science 2000, 290, 521–523. [Google Scholar] [CrossRef]
- Fitter, A. Ecology: Making allelopathy respectable. Science 2003, 301, 1337–1338. [Google Scholar] [CrossRef]
- Duke, S.O. Ecophysiological aspects of allelopathy. Planta 2003, 217, 529–539. [Google Scholar] [CrossRef]
- Bais, H.P. Allelopathy and exotic plant invasion: From molecules and genes to species interactions. Science 2003, 301, 1377–1380. [Google Scholar] [CrossRef]
- Weir, T.L.; Park, S.-W.; Vivanco, J.M. Biochemical and physiological mechanisms mediated by allelochemicals. Curr. Opin. Plant Biol. 2004, 7, 472–479. [Google Scholar] [CrossRef] [PubMed]
- Vestergård, M.; Rønn, R.; Ekelund, F. Above–belowground interactions govern the course and impact of biological invasions. AoB Plants 2015, 7, plv025. [Google Scholar] [CrossRef] [PubMed] [Green Version]
- Cheng, F.; Cheng, Z. Research progress on the use of plant allelopathy in agriculture and the physiological and ecological mechanisms of allelopathy. Front. Plant Sci. 2015, 6, 1020. [Google Scholar] [CrossRef] [PubMed] [Green Version]
- Kong, C.-H.; Xuan, T.D.; Khanh, T.D.; Tran, H.-D.; Trung, N.T. Allelochemicals and signaling chemicals in plants. Molecules 2019, 24, 2737. [Google Scholar] [CrossRef] [PubMed] [Green Version]
- Šoln, K.; Klemenčič, M.; Koce, J.D. Plant cell responses to allelopathy: From oxidative stress to programmed cell death. Protoplasma 2022, 259, 1111–1124. [Google Scholar] [CrossRef]
- Aci, M.M.; Sidari, R.; Araniti, F.; Lupini, A. Emerging trends in allelopathy: A genetic perspective for sustainable agriculture. Agronomy 2022, 12, 2043. [Google Scholar] [CrossRef]
- Yang, Y.; Olatunde, O.; Yang, L.; Olatunde, Y.; Lu, Y. Progress of chemical components and biological activities of Lonicera maackii. Mathews J. Cancer Sci. 2018, 3, 016. Available online: https://www.mathewsopenaccess.com/full-text/progress-of-chemical-components-and-biological-activities-of-lonicera-maackii (accessed on 25 November 2022).
- Cipollini, K.; Titus, K.Y.; Wagner, C. Allelopathic effects of invasive species (Alliaria petiolata, Lonicera maackii, Ranunculus ficaria) in the Midwestern United States. Allelopath. J. 2012, 29, 63–76. [Google Scholar]
- Kobayashi, K. Factors affecting phytotoxic activity of allelochemicals in soil. Weed Biol. Manag. 2004, 4, 1–7. [Google Scholar] [CrossRef]
- Cipollini, D.; Rigsby, C.M.; Barto, E.K. Microbes as targets and mediators of allelopathy in plants. J. Chem. Ecol. 2012, 38, 714–727. [Google Scholar] [CrossRef] [PubMed]
- Shannon-Firestone, S.; Firestone, J. Allelopathic potential of invasive species is determined by plant and soil community context. Plant Ecol. 2015, 216, 491–502. [Google Scholar] [CrossRef]
- Ali, J.; Lieurance, D.; Cipollini, D. Soil biota affect mycorrhizal infection and growth of Impatiens capensis and alter the effects of Lonicera maackii rhizosphere extracts. J. Torrey Bot. Soc. 2015, 142, 1–11. [Google Scholar] [CrossRef]
- Blum, U. Effects of microbial utilization of phenolic acids and their phenolic acid breakdown products on allelopathic interactions. J. Chem. Ecol. 1998, 24, 685–708. [Google Scholar] [CrossRef]
- Blum, U.; Shafer, S.R.; Lehman, M.E. Evidence for inhibitory allelopathic interactions involving phenolic acids in field soils: Concepts vs. an experimental model. Crit. Rev. Plant Sci. 1999, 18, 673–693. [Google Scholar] [CrossRef]
- Ohno, T. Oxidation of phenolic acid derivatives by soil and its relevance to allelopathic activity. J. Environ. Qual. 2001, 30, 1631–1635. [Google Scholar] [CrossRef]
- Chaves, N.; Sosa, T.; Escudero, J.C. Plant growth inhibiting flavonoids in the exudate of Cistus ladanifer and in associated soils. J. Chem. Ecol. 2001, 27, 623–631. [Google Scholar] [CrossRef]
- Elmore, C.D. Inhibition of Turnip (Brassica rapa) seed germination by velvetleaf (Abutilon theophrasti) seed. Weed Sci. 1980, 28, 658–660. [Google Scholar] [CrossRef]
- Singh, H.P.; Batish, D.R.; Pandher, J.K.; Kohli, R.K. Phytotoxic effects of Parthenium hysterophorus residues on three Brassica species. Weed Biol. Manag. 2005, 5, 105–109. [Google Scholar] [CrossRef]
- Xuan, T.D.; Elzaawely, A.A.; Deba, F.; Tawata, S. Mimosine in Leucaena as a potent bio-herbicide. Agron. Sustain. Dev. 2006, 26, 89–97. [Google Scholar] [CrossRef] [Green Version]
- Swapnal, S.; Siddiqui, M.B. Allelopathic effect by aqueous extracts of different parts of Croton bonplandianum Baill. on some crop and weed plants. J. Agric. Ext. Rural Dev. 2010, 2, 022–028. [Google Scholar]
- Huang, W.; Hu, T.; Zhang, N.; Xiao, Y.; He, Y.; Li, Z.; Ding, W. Effects of leaf litter of Cinnamomum septentrionale on growth and resistance physiology of Brassica rapa in the decomposition process of litter. Acta Ecol. Sin. 2012, 32, 3883–3891. [Google Scholar] [CrossRef] [Green Version]
- Cui, C.; Cai, J.; Zhang, S. Allelopathic effects of walnut (Juglans regia L.) rhizospheric soil extracts on germination and seedling growth of turnip (Brassica rapa L.). Allelopath. J. 2013, 32, 37–47. [Google Scholar]
- Barnum, K.; Franks, S.J. Seed extracts impede germination in Brassica rapa plants. Int. J. Plant Biol. 2013, 4, e2. [Google Scholar] [CrossRef]
- Chaves, N.; Escudero, J.C.; Gutiérrez-Merino, C. Seasonal variation of exudate of Cistus ladanifer. J. Chem. Ecol. 1993, 19, 2577–2591. [Google Scholar] [CrossRef]
- Witzell, J.; Gref, R.; Näsholm, T. Plant-part specific and temporal variation in phenolic compounds of boreal bilberry (Vaccinium myrtillus) plants. Biochem. Syst. Ecol. 2003, 31, 115–127. [Google Scholar] [CrossRef]
- Elger, A.; Lemoine, D.G.; Fenner, M.; Hanley, M.E. Plant ontogeny and chemical defence: Older seedlings are better defended. Oikos 2009, 118, 767–773. [Google Scholar] [CrossRef]
- Kong, D.; Li, Y.; Bai, M.; He, H.; Liang, G.; Wu, H. Correlation between the dynamic accumulation of the main effective components and their associated regulatory enzyme activities at different growth stages in Lonicera japonica Thunb. Ind. Crops Prod. 2017, 96, 16–22. [Google Scholar] [CrossRef]
- Li, Y.; Kong, D.; Bai, M.; He, H.; Wang, H.; Wu, H. Correlation of the temporal and spatial expression patterns of HQT with the biosynthesis and accumulation of chlorogenic acid in Lonicera japonica flowers. Hortic. Res. 2019, 6, 73. [Google Scholar] [CrossRef] [Green Version]
- Loreto, F.; Dicke, M.; Schnitzler, J.-P.; Turlings, T.C.J. Plant volatiles and the environment. Plant Cell Environ. 2014, 37, 1905–1908. [Google Scholar] [CrossRef]
- Verma, N.; Shukla, S. Impact of various factors responsible for fluctuation in plant secondary metabolites. J. Appl. Res. Med. Aromat. Plants 2015, 2, 105–113. [Google Scholar] [CrossRef]
- Blanchard, M.; Bowers, M.D. Critical phenological events affect chemical defense of plant tissues: Iridoid glycosides in a woody shrub. J. Chem. Ecol. 2020, 46, 206–216. [Google Scholar] [CrossRef] [PubMed]
- Li, Y.; Kong, D.; Fu, Y.; Sussman, M.R.; Wu, H. The Effect of developmental and environmental factors on secondary metabolites in medicinal plants. Plant Physiol. Biochem. 2020, 148, 80–89. [Google Scholar] [CrossRef] [PubMed]
- Ponder, A.; Najman, K.; Aninowski, M.; Leszczyńska, J.; Głowacka, A.; Bielarska, A.M.; Lasinskas, M.; Hallmann, E. Polyphenols content, antioxidant properties and allergenic potency of organic and conventional blue honeysuckle berries. Molecules 2022, 27, 6083. [Google Scholar] [CrossRef] [PubMed]
- Prinsloo, G.; Nogemane, N. The Effects of season and water availability on chemical composition, secondary metabolites and biological activity in plants. Phytochem. Rev. 2018, 17, 889–902. [Google Scholar] [CrossRef]
- Liebelt, D.J.; Jordan, J.T.; Doherty, C.J. Only a matter of time: The impact of daily and seasonal rhythms on phytochemicals. Phytochem. Rev. 2019, 18, 1409–1433. [Google Scholar] [CrossRef]
- Holopainen, J.K.; Virjamo, V.; Ghimire, R.P.; Blande, J.D.; Julkunen-Tiitto, R.; Kivimäenpää, M. Climate Change effects on secondary compounds of forest trees in the Northern hemisphere. Front. Plant Sci. 2018, 9, 1445. [Google Scholar] [CrossRef] [Green Version]
- Beran, F.; Köllner, T.G.; Gershenzon, J.; Tholl, D. Chemical convergence between plants and insects: Biosynthetic origins and functions of common secondary metabolites. New Phytol. 2019, 223, 52–67. [Google Scholar] [CrossRef] [Green Version]
- Erb, M.; Kliebenstein, D.J. Plant secondary metabolites as defenses, regulators, and primary metabolites: The blurred functional trichotomy. Plant Physiol. 2020, 184, 39–52. [Google Scholar] [CrossRef]
- Landi, M.; Zivcak, M.; Sytar, O.; Brestic, M.; Allakhverdiev, S.I. Plasticity of photosynthetic processes and the accumulation of secondary metabolites in plants in response to monochromatic light environments: A review. Biochim. Biophys. Acta Bioenerg. 2020, 1861, 148131. [Google Scholar] [CrossRef] [PubMed]
- Monson, R.K.; Trowbridge, A.M.; Lindroth, R.L.; Lerdau, M.T. Coordinated resource allocation to plant growth–defense tradeoffs. New Phytol. 2021, 233, 1051–1066. [Google Scholar] [CrossRef] [PubMed]
- Kant, M.R.; Schuurink, R.C. Life stage-dependent genetic traits as drivers of plant–herbivore interactions. Curr. Opin. Biotechnol. 2021, 70, 234–240. [Google Scholar] [CrossRef] [PubMed]
- Hierro, J.L.; Callaway, R.M. Allelopathy and exotic plant invasion. Plant Soil 2003, 256, 29–39. [Google Scholar] [CrossRef]
- Flamini, G.; Braca, A.; Cioni, P.J.; Morelli, I. Three new flavonoids and other constituents from Lonicera implexa. J. Nat. Prod. 1997, 60, 449–452. [Google Scholar] [CrossRef]
- Reigosa, M.J.; Sánchez-Moreiras, A.; González, L. Eco-physiological approach in allelopathy. Crit. Rev. Plant Sci. 1999, 18, 577–608. [Google Scholar] [CrossRef]
- Patterson, D.T. Effects of allelopathic chemicals on growth and physiological responses of soybean (Glycine max). Weed Sci. 1981, 29, 53–59. [Google Scholar] [CrossRef]
- Li, Z.-H.; Wang, Q.; Ruan, X.; Pan, C.-D.; Jiang, D.-A. Phenolics and plant allelopathy. Molecules 2010, 15, 8933–8952. [Google Scholar] [CrossRef] [Green Version]
- John, J.; Sarada, S. Role of phenolics in allelopathic interactions. Allelopath. J. 2012, 29, 215–230. [Google Scholar]
- Mitrović, M.; Jarić, S.; Djurdjević, L.; Karadžić, B.; Gajić, G.; Kostić, O.; Oberan, L.J.; Pavlović, D.; Pavlović, M.; Pavlović, P. Allelopathic and environmental implications of plant phenolic compounds. Allelopath. J. 2012, 29, 177–197. [Google Scholar]
- Lupini, A.; Sorgonà, A.; Princi, M.P.; Sunseri, F.; Abenavoli, M.R. Morphological and physiological effects of trans-cinnamic acid and its hydroxylated derivatives on maize root types. Plant Growth Regul. 2015, 78, 263–273. [Google Scholar] [CrossRef]
- Macías, F.A.; Mejías, F.J.; Molinillo, J.M. Recent advances in allelopathy for weed control: From knowledge to applications. Pest Manag. Sci. 2019, 75, 2413–2436. [Google Scholar] [CrossRef] [PubMed]
- Chen, L.; Li, J.; Zhu, Y.; Guo, L.; Ji, R.; Miao, Y.; Guo, L.; Du, H.; Liu, D. Caffeic acid, an allelochemical in Artemisia argyi, inhibits weed growth via suppression of mitogen-activated protein kinase signaling pathway and the biosynthesis of gibberellin and phytoalexin. Front. Plant Sci. 2022, 12, 802198. [Google Scholar] [CrossRef] [PubMed]
- Lieurance, D.; Chakraborty, S.; Whitehead, S.R.; Powell, J.R.; Bonello, P.; Bowers, M.D.; Cipollini, D. Comparative herbivory rates and secondary metabolite profiles in the leaves of native and non-native Lonicera species. J. Chem. Ecol. 2015, 41, 1069–1079. [Google Scholar] [CrossRef] [PubMed]
- Weir, T.L.; Bais, H.P.; Stull, V.J.; Callaway, R.M.; Thelen, G.C.; Ridenour, W.M.; Bhamidi, S.; Stermitz, F.R.; Vivanco, J.M. Oxalate contributes to the resistance of Gaillardia grandiflora and Lupinus sericeus to a phytotoxin produced by Centaurea maculosa. Planta 2006, 223, 785–795. [Google Scholar] [CrossRef]
- Orr, S.P.; Rudgers, J.A.; Clay, K. Invasive plants can inhibit native tree seedlings: Testing potential allelopathic mechanisms. Plant Ecol. 2005, 181, 153–165. [Google Scholar] [CrossRef]
- Wu, A.-P.; Li, Z.-L.; He, F.-F.; Wang, Y.-H.; Dong, M. Screening allelochemical-resistant species of the alien invasive Mikania micrantha for restoration in South China. PLoS ONE 2015, 10, e0132967. [Google Scholar] [CrossRef] [Green Version]
- Perry, L.G.; Johnson, C.; Alford, E.R.; Vivanco, J.M.; Paschke, M.W. Screening of grassland plants for restoration after spotted knapweed invasion. Restor. Ecol. 2005, 13, 725–735. [Google Scholar] [CrossRef]
- Cheng, F.; Cheng, Z.-H.; Meng, H.-W. Transcriptomic insights into the allelopathic effects of the garlic allelochemical diallyl disulfide on tomato roots. Sci. Rep. 2016, 6, 38902. [Google Scholar] [CrossRef] [Green Version]
- Rood, S.B.; Pearce, D.; Williams, P.H.; Pharis, R.P. A gibberellin-deficient Brassica mutant-rosette. Plant Physiol. 1989, 89, 482–487. [Google Scholar] [CrossRef] [Green Version]
- Iwashina, T. Flavonoid function and activity to plants and other organisms. Biol. Sci. Space 2003, 17, 24–44. [Google Scholar] [CrossRef] [PubMed] [Green Version]
- El Mihyaoui, A.; Esteves da Silva, J.C.G.; Charfi, S.; Candela Castillo, M.E.; Lamarti, A.; Arnao, M.B. Chamomile (Matricaria chamomilla L.): A review of ethnomedicinal use, phytochemistry and pharmacological Uses. Life 2022, 12, 479. [Google Scholar] [CrossRef] [PubMed]
- Shakeel, F.; Alshehri, S.; Ibrahim, M.A.; Elzayat, E.M.; Altamimi, M.A.; Mohsin, K.; Alanazi, F.K.; Alsarra, I.A. Solubility and Thermodynamic Parameters of Apigenin in Different Neat Solvents at Different Temperatures. J. Mol. Liq. 2017, 234, 73–80. [Google Scholar] [CrossRef]
- National Center for Biotechnology Information (NCBI). PubChem Compound Summary for CID 5280443, Apigenin. Available online: https://pubchem.ncbi.nlm.nih.gov/compound/Apigenin (accessed on 13 January 2023).
- Shakeel, F.; Haq, N.; Alshehri, S.; Ibrahim, M.A.; Elzayat, E.M.; Altamimi, M.A.; Mohsin, K.; Alanazi, F.K.; Alsarra, I.A. Solubility, Thermodynamic Properties and Solute-Solvent Molecular Interactions of Luteolin in Various Pure Solvents. J. Mol. Liq. 2018, 255, 43–50. [Google Scholar] [CrossRef]
- National Center for Biotechnology Information (NCBI). PubChem Compound Summary for CID 5280445, Luteolin. Available online: https://pubchem.ncbi.nlm.nih.gov/compound/Luteolin (accessed on 13 January 2023).
- Bi, B.; Tang, J.; Han, S.; Guo, J.; Miao, Y. Sinapic acid or its derivatives interfere with abscisic acid homeostasis during Arabidopsis thaliana seed germination. BMC Plant Biol. 2017, 17, 99. [Google Scholar] [CrossRef] [Green Version]
- Azim, U.M. Allelopathy in forested ecosystems. In Allelopathy in Sustainable Agriculture and Forestry; Zeng, R.S., Mallik, A.U., Luo, S.M., Eds.; Springer: New York, NY, USA, 2008; pp. 363–377. [Google Scholar]
- Scavo, A.; Mauromicale, G. Crop allelopathy for sustainable weed management in agroecosystems: Knowing the present with a view to the future. Agronomy 2021, 11, 2104. [Google Scholar] [CrossRef]
- Hussain, M.I.; Abideen, Z.; Danish, S.; Asghar, M.A.; Iqbal, K. Integrated weed management for sustainable agriculture. Sustain. Agric. Rev. 2021, 52, 367–393. [Google Scholar] [CrossRef]
- Macías, F.A.; Marín, D.; Oliveros-Bastidas, A.; Varela, R.M.; Simonet, A.M.; Carrera, C.; Molinillo, J.M. Allelopathy as a new strategy for sustainable ecosystems development. Biol. Sci. Space 2003, 17, 18–23. [Google Scholar] [CrossRef] [Green Version]
- Bhadoria, P.B.S. Allelopathy: A natural way towards weed management. Am. J. Exp. Agric. 2011, 1, 7–20. [Google Scholar] [CrossRef]

Disclaimer/Publisher’s Note: The statements, opinions and data contained in all publications are solely those of the individual author(s) and contributor(s) and not of MDPI and/or the editor(s). MDPI and/or the editor(s) disclaim responsibility for any injury to people or property resulting from any ideas, methods, instructions or products referred to in the content. |
© 2023 by the authors. Licensee MDPI, Basel, Switzerland. This article is an open access article distributed under the terms and conditions of the Creative Commons Attribution (CC BY) license (https://creativecommons.org/licenses/by/4.0/).
Share and Cite
Barta, C.É.; Jenkins, B.C.; Lindstrom, D.S.; Zahnd, A.K.; Székely, G. The First Evidence of Gibberellic Acid’s Ability to Modulate Target Species’ Sensitivity to Honeysuckle (Lonicera maackii) Allelochemicals. Plants 2023, 12, 1014. https://doi.org/10.3390/plants12051014
Barta CÉ, Jenkins BC, Lindstrom DS, Zahnd AK, Székely G. The First Evidence of Gibberellic Acid’s Ability to Modulate Target Species’ Sensitivity to Honeysuckle (Lonicera maackii) Allelochemicals. Plants. 2023; 12(5):1014. https://doi.org/10.3390/plants12051014
Chicago/Turabian StyleBarta, Csengele Éva, Brian Colby Jenkins, Devon Shay Lindstrom, Alyka Kay Zahnd, and Gyöngyi Székely. 2023. "The First Evidence of Gibberellic Acid’s Ability to Modulate Target Species’ Sensitivity to Honeysuckle (Lonicera maackii) Allelochemicals" Plants 12, no. 5: 1014. https://doi.org/10.3390/plants12051014
APA StyleBarta, C. É., Jenkins, B. C., Lindstrom, D. S., Zahnd, A. K., & Székely, G. (2023). The First Evidence of Gibberellic Acid’s Ability to Modulate Target Species’ Sensitivity to Honeysuckle (Lonicera maackii) Allelochemicals. Plants, 12(5), 1014. https://doi.org/10.3390/plants12051014










